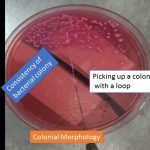

Collection Group: Clinical Bacteriology
Colony Morphology of Bacteria: Introduction, Types and Special Features of Bacteria
Introduction of Colony morphology Colony morphology of bacteria is the...
Introduction of Colony morphology Colony morphology of bacteria is the...
Diphtheria Bacillus Versus Diphtheroids: Introduction and Differences in Details
 Introduction of Diphtheria bacillus versus Diphtheroids Diphtheria bacillus versus Diphtheroids can...
Introduction of Diphtheria bacillus versus Diphtheroids Diphtheria bacillus versus Diphtheroids can...
Streptococcus pneumoniae Versus Viridans streptococci: Introduction and Differentiating Features
 Introduction of Streptococcus pneumoniae versus Viridans streptococci Streptococcus pneumoniae...
Introduction of Streptococcus pneumoniae versus Viridans streptococci Streptococcus pneumoniae...
